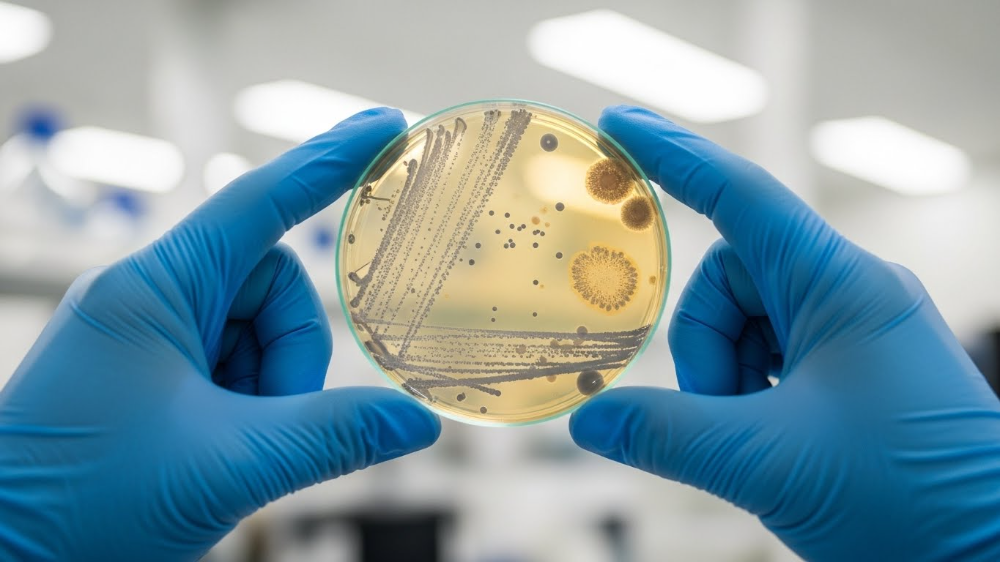

Биотехнологии и глубокая переработка зерна: новые проекты импортозамещения в России
2 декабря 2025, 16:00
Развитие биотехнологических производств становится приоритетом государственной политики в сельскохозяйственном секторе. Министр сельского хозяйства Оксана Лут представила масштабный план развития современных технологий производства и глубокой переработки в агропромышленном комплексе как основы продовольственной безопасности России и доступности продуктов питания для населения
Глава Минсельхоза Оксана Лут выступила на «правительственном часе» в Государственной Думе 12 ноября 2025 года. Представляем основные тезисы ее доклада.
Биотехнологии для кормовой и пищевой промышленности
Россия в настоящее время зависит от импорта по большинству видов биотехнологической продукции, необходимой для кормовой и пищевой промышленности. Речь идет о органических аминокислотах, ферментах, витаминах, закваски и модифицированных крахмалах — критически важных компонентах, без которых невозможно развивать высокотехнологичное животноводство и пищевую промышленность.
Устранение зависимости требует создания дорогостоящих и наукоемких производств. Это сложная задача, но ее решение открывает огромные возможности для импортозамещения и экспорта.

Проекты
Ряд проектов уже реализуется. Первый крупный проект касается производства закваски — микробиологических культур, без которых невозможно современное пищевое производство от хлеба до молочной продукции. На территории Ярославской области строится новый завод по производству закваски, который позволит существенно снизить зависимость от импорта этих культур.
В Ростове реализуется проект по производству модифицированных крахмалов — специальных веществ, которые используются в пищевой промышленности для улучшения текстуры, консистенции и хранения различных продуктов. Модифицированные крахмалы — это стратегически важный компонент, спрос на который постоянно растет.
Развитие производства органических кислот — еще одно направление импортозамещения. В Туле и Воронеже реализуются проекты по производству лимонной кислоты, которая широко используется в пищевой промышленности, фармацевтике и других отраслях. В Калуге строится производство аскорбиновой кислоты (витамина C) — одного из самых востребованных витаминов в производстве биодобавок и пищевых продуктов.
Одним из самых амбициозных проектов является строительство завода по производству кормовых ферментов в Белгороде. Это особенно важно, поскольку данный проект основан полностью на отечественных разработках, а не на импортных технологиях.
Ферменты разработаны учеными двух ведущих российских институтов: Института цитологии и генетики Сибирского отделения РАН и Федерального исследовательского центра биотехнологии РАН. В течение трёх лет российские ученые самостоятельно разработали штаммы-продуценты для всех необходимых ферментов, используемых как в животноводстве, так и в человеческой медицине.
Завод должен выйти на проектную мощность в 2027 году, что обеспечит кормовую промышленность России критически важными компонентами и создаст резерв для экспорта.
Татарстан становится центром производства аминокислот — одних из самых важных компонентов кормовой промышленности. Аминокислоты определяют качество кормов для животных и, следовательно, качество и количество полученной продукции.
«Реализация этих и других проектов позволит в разы повысить нашу самообеспеченность критически важными компонентами. Здесь также хочу поблагодарить депутатов за принятие Федерального закона, который дал возможность оказывать государственную поддержку производителям кормовых добавок и ветпрепаратов. Ранее это было невозможно», – объяснила министр.

Перспективы развития отрасли
Закрыть потребность в лизине
Лизин — первая по объёму аминокислота, потребляемая в кормовой промышленности. На данный момент Россия закрывает 2/3 потребности в лизине за счёт собственного производства. Оставшуюся треть приходится импортировать с территории Беларуси, где располагается крупнейшее современное предприятие по производству лизина.
Развитие производства треонина
Треонин — третья по объёму потребления аминокислота. Россия в настоящее время рассматривает возможность строительства проекта по производству треонина на территории Воронежской области. Оксана Лут отметила, что страна не полностью обеспечена кормовыми аминокислотами: «Мы закрываем внутренним производством 2/3 потребности в лизине. Оставшийся лизин мы импортируем с территории Беларуси — там крупнейшее современное предприятие по производству лизина. Метионин — это старое предприятие еще Советского Союза в Волгоградской области, которое является, на наш взгляд, менее эффективным. Сейчас мы выходим на строительство нового завода по метионину в республике Татарстан, который не только закроет всю потребность России, но и будет обладать экспортным потенциалом по второй аминокислоте. Что касается треонина, третьей аминокислоты по объему потребления, мы сейчас рассматриваем возможность строительства проекта на территории Воронежской области. Также в республике Татарстан прорабатывается проект и идёт инжиниринг для производства малотоннажных аминокислот».

Господдержка производства
Меры поддержки этих проектов предусмотрены в рамках национального проекта «Биоэкономика», который включает:
- льготное кредитование для инвестиционных проектов в биотехнологиях
- возмещение капитальных затрат – часть расходов на строительство и оборудование компенсирует государство
- субсидии на научные разработки в рамках Федеральной научно-технической программы и национального проекта
Комплексный подход обеспечивает финансовую поддержку как на этапе разработки технологии, так и на этапе ее коммерциализации.
«Сейчас мы делаем часть проектов на импортных технологиях. В частности, штаммы-продуценты, присутствующие в аминокислотах, это импортные китайские технологии, и Китай осуществляет их трансфер. Однако, например, ферментный завод, который строится в Белгороде, – это разработка наших ученых, Института цитологии и генетики СО РАН и ФИЦ Биотехнологии РАН, которые за три года самостоятельно разработали штаммы-продуценты для всех необходимых человеку и животным ферментов. На основании отечественной технологии будет построен завод в Белгороде, на проектную мощность он должен выйти в 2027 году», – подчеркнула министр.
Оксана Лут особо подчеркнула значение принятия Федерального закона, который дал возможность оказывать государственную поддержку производителям кормовых добавок и ветпрепаратов. Ранее это было невозможно, так что принятие закона стало важной вехой в развитии этого сегмента.
Развитие биотехнологических производств имеет огромное значение не только для импортозамещения, но и для всей структуры агропромышленного комплекса:
- Кормовая промышленность получит критически важные компоненты для производства качественных кормов
- Животноводство сможет повысить производительность и качество выпускаемой продукции
- Пищевая промышленность получит отечественные компоненты для создания продуктов с улучшенными характеристиками
- Фармацевтика получит доступ к отечественным витаминам и кислотам
- Экспортный потенциал откроет новые рынки для российской продукции
Глубокая переработка зерна и развитие биотехнологий — это не просто национальные проекты, это основа будущего развития российского сельского хозяйства и пищевой промышленности.
*Своё Медиа благодарит Ассоциацию предприятий глубокой переработки зерна (Союзкрахмал) за помощь в подготовке статьи
Читайте также:
- Глубокая переработка зерна: внутренний спрос и экспортный потенциал
- Рынок глубокой переработки зерна в России
- Топ 3 перспективных продуктов глубокой переработки зерна
- Корма для трепанга: сахарина, цистозира или анфельция
- Селекция зерновых Юго-Востока России: успехи и вызовы
- В Канзасе разрабатывают калькулятор лизина для свиней
- Масличные vs зерновые: прогноз рентабельности на 2025–2026 сельхозгод от эксперта
Комментарии
Биотехнологии и глубокая переработка зерна: новые проекты импортозамещения в России
Поделиться в социальных сетях
Мы будем рады пригласить вас к нам на эфиры или оформить ваши идеи в форме статьи, новости или поста в социальных сетях
Отправляя заявку, вы соглашаетесь на обработку персональных данных соответственно требованиям ФЗ «О персональных данных», а также на информирование о продуктах и услугах банка